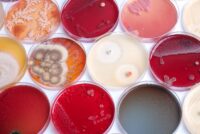
Renaissance BioScience secures Genome BC funding to build yeast discovery platform

On the edge of agribusiness journalism
In the dynamic world of agriculture, staying informed is not just an option but a necessity for those directly involved in the industry—from sprawling orchards and farm owners to individual vegetable growers and casual gardeners. Fertilizer Daily provides comprehensive coverage of the latest happenings in agribusiness, ensuring its readers are always up-to-date. Beyond just news, we offer in-depth interviews with key figures in the agriculture industry. These discussions shed light on the strategies and insights of leading professionals, offering readers perspectives that are both influential and educational.
Our editorial team is committed to delivering timely, relevant, and concise information, making it an invaluable tool for anyone connected to the field of agriculture. Our focused approach ensures that every article and feature not only informs but also engages and empowers our audience, fostering a well-informed community ready to face the challenges and opportunities of the agriculture sector.